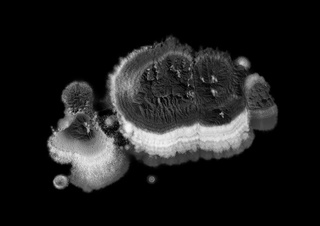

mittendrin - TU Dortmund
Kolloquium 2020
<h1>Kolloquium 2020</h1>
<h2>Sommersemester 2020</h2>
Kolloquium 2020
Sommersemester 2020
Das Kolloquium ermöglicht den Diskurs über zeitgenössische Fotografie und bietet Raum für Fragen und Antworten zu individuellen fotografischen Projekten im Gruppengespräch. Die Veranstaltung begleitet außerdem bei der Vorbereitung auf Ausstellungen, Prüfungen und Bachelor- sowie Masterarbeiten.
Dozent: Felix Dobbert

JavaScript is turned off.
Please enable JavaScript to view this site properly.